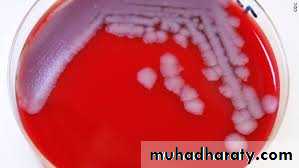

Spore-Forming Gram-Positive Bacilli
Bacillus SpeciesBacillus Species
B anthracis, which causes anthrax, is the principal pathogen of the genus. It's a major agent of bioterrorism and biologic warfare.Bacillus cereus causes food poisoning and occasionally eye or other localized infections.
Most members of this genus are saprophytic organisms prevalent in soil, water, and air and on vegetation, such as Bacillus cereus and Bacillus subtilis. Such organisms may occasionally produce disease in immuno-compromised humans (e.g, meningitis, endocarditis).
Morphology & Identification
Typical OrganismsThe typical cells, measuring 1 x 3–4µm, large, gram-positive rods occurring in chains, have square ends and are arranged in long chains; spores location is different could be central or terminal not projecting.On gram stain the spore not stained and appear as empty space.
Culture
Bacillus is aerobic, Colonies of B anthracis are round. Hemolysis is uncommon with B anthracis but common with B cereus and the saprophytic bacilli.
Gelatin is liquefied.
Growth Characteristics
The spores are resistant to environmental changes, withstand dry heat and certain chemical disinfectants for moderate periods, and persist for years in dry earth. Animal products contaminated with anthrax spores (eg, hides, bristles, hair, wool, bone) can be sterilized by autoclaving.Bacillus anthracis
PathogenesisAnthrax is primarily a disease of herbivores. Humans become infected incidentally by contact with infected animals or their products.
In humans, the infection is usually acquired by the entry of spores through injured skin (cutaneous anthrax) or rarely the mucous membranes (gastrointestinal anthrax), or by inhalation of spores into the lung (inhalation anthrax).
In humans, approximately 95% of cases are cutaneous anthrax and 5% are inhalation. Gastrointestinal anthrax is very rare; it has been reported where people have eaten meat from infected animals.
The spores germinate in the tissue at the site of entry, and growth of the vegetative organisms results in formation of a gelatinous edema and congestion. Bacilli spread via lymphatics to the bloodstream.
B anthracis capsule is antiphagocytic.
Anthrax toxin is made up of three proteins: protective antigen (PA), edema factor (EF), and lethal factor (LF).
LF plus PA form lethal toxin, which is a major virulence factor and cause of death in infected animals and humans.
When injected into laboratory animals (eg, rats) the lethal toxin can quickly kill the animals.
Inhalation anthrax (wool sorter disease)
the spores from the dust of wool, hair, or hides are inhaled, phagocytosed in the lungs, and transported by the lymphatic drainage to the mediastinal lymph nodes, where germination occurs. This is followed by toxin production and the development of hemorrhagic mediastinitis and sepsis, which are usually rapidly fatal.The incubation period in inhalation anthrax may be as long as 6 weeks. The early clinical manifestations are associated with marked hemorrhagic necrosis and edema of the mediastinum. Substernal pain may be prominent, and there is pronounced mediastinal widening visible on x-ray chest films. Hemorrhagic pleural effusions follow involvement of the pleura. Sepsis occurs, and there may be hematogenous spread.
Cutaneous anthrax
Cutaneous anthrax generally occurs on exposed surfaces of the arms or hands, followed in frequency by the face and neck. A pruritic papule develops 1–7 days after entry of the organisms or spores through a scratch. Initially it resembles an insect bite.The papule rapidly changes into a vesicle or small ring of vesicles that coalesce, and a necrotic ulcer develops. The lesions typically are 1–3 cm in diameter and have a characteristic central black eschar. Marked edema occurs. Lymphangitis and systemic signs and symptoms of fever, malaise, and headache may occur. After 7–10 days the eschar dries, loosens, and separates; healing is by granulation and leaves a scar.
Antibiotic therapy does not appear to change the natural progression of the disease. In as many as 20% of patients, cutaneous anthrax can lead to sepsis, the consequences of systemic infection—including meningitis—and death.
Gastrointestinal anthrax is extremely uncommon. Abdominal pain, vomiting, and bloody diarrhea are clinical signs.
Diagnostic Laboratory Tests
Specimens to be examined are fluid or pus from a local lesion, blood, and sputum.Stained smears show chains of large gram-positive rods. Anthrax can be identified in dried smears by immunofluorescence staining techniques.
Culture: blood agar plates, the organisms produce nonhemolytic gray to white colonies with a rough texture. Gram stain shows large gram-positive rods.
Biochemical tests: in semisolid medium, anthrax bacilli are always nonmotile, whereas related organisms (eg, B cereus) exhibit motility by "swarming."
Catalase positive , starch hydrolysis positive
Virulent anthrax cultures kill mice or guinea pigs upon intraperitoneal injection.
An enzyme-linked immunoassay (ELISA)
measure antibodies against edema and lethal toxins.
Acute and convalescent sera obtained 4 weeks apart should be tested. A positive result is a fourfold change or a single titer of greater than 1:32.
Nucleic acid amplification assays available.
Resistance & Immunity
The current vaccine contains cell-free filtrates of a toxigenic nonencapsulated nonvirulent strain of B anthracis. The amount of PA present per dose is unknown and all three toxins' components (LF, EF, and PA) are present. The vaccine is available only to persons at risk for repeated exposure to B anthracis.Treatment
Many antibiotics are effective but treatment must be started early.
- Ciprofloxacin is recommended for treatment;
-Doxycycline, erythromycin, or ciprofloxacin may be effective alternatives to penicillin.
Epidemiology, Prevention, & Control
Soil is contaminated with anthrax spores from the carcasses of dead animals. These spores remain viable for decades. Perhaps spores can germinate in soil at pH 6.5 at proper temperature.Control measures include
(1) disposal of animal carcasses by burning or by deep burial.
(2) decontamination (usually by autoclaving) of animal products.
(3) protective clothing and gloves for handling potentially infected materials.
(4) active immunization of domestic animals with live attenuated vaccines. Persons with high occupational risk should be immunized.
Bacillus cereus
Food poisoning caused by B cereus has two distinct forms: the emetic type, associated with fried rice, and the diarrheal type, associated with meat dishes and sauces.B cereus produces toxins that cause disease.
The emetic form is manifested by nausea, vomiting, abdominal cramps, and occasionally diarrhea and is self-limiting, with recovery occurring within 24 hours. It begins 1–5 hours after ingestion of rice and occasionally pasta dishes. B cereus spores germinate, and the vegetative cells produce the toxin during log-phase growth or during sporulation.
The diarrheal form has an incubation period of 1–24 hours and is manifested by profuse diarrhea with abdominal pain and cramps; fever and vomiting are uncommon. The enterotoxin may be performed in the food or produced in the intestine.
B. cereus is an important cause of eye infections, severe keratitis, endophthalmitis, and panophthalmitis.
Systemic infections, including endocarditis, meningitis, osteomyelitis, and pneumonia; the presence of a medical device or intravenous drug use predisposes to these infections.
B cereus is resistant to penicillins and cephalosporins. Serious non food-borne infections should be treated with vancomycin or clindamycin with or without an aminoglycoside
Other Bacillus species are rarely associated with human disease.
Starch hydrolysis test (genus Bacillus)
Spore staining method (genus bacillus)Red bacilli
Green endospore
Bacilli arrange in
Short chains
. Free green spores